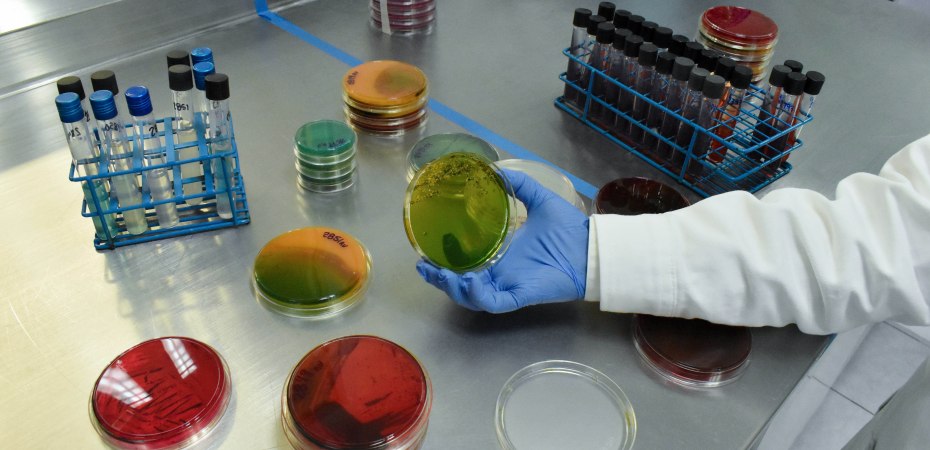

*El Servicio Nacional de Sanidad, Inocuidad y Calidad Agroalimentaria (Senasica) celebra dos foros virtuales con especialistas nacionales e internacionales, en los que aborda la importancia de la Resistencia a los Antimicrobianos (RAM).
*Del 23 al 24 de noviembre se realizará el foro: “Una Perspectiva Ambiental”, en el que por primera vez en México se hablará de la importancia de la inocuidad de los alimentos para atacar este problema global.
*De acuerdo con la Organización Mundial de Salud, en 2050 la presencia de las “superbacterias” cada año podrían ser causa de muerte de más de 10 millones de seres humanos.
En el marco de la Semana Mundial de Concientización sobre la Resistencia a los Antimicrobianos (RAM), la Secretaría de Agricultura y Desarrollo Rural celebra dos foros virtuales en los que expertos del sector público y privado abordan la problemática desde la perspectiva de la salud animal y del medio ambiente.
En los eventos, organizados a través de las direcciones generales de Salud Animal (DGSA) y de Inocuidad Agroalimentaria, Acuícola y Pesquera (DGIAAP) del Servicio Nacional de Sanidad, Inocuidad y Calidad Agroalimentaria (Senasica), participan especialistas, profesionales de la salud pública, animal y ambiental, y de organizaciones a nivel nacional e internacional.
El primer foro, organizado por el Centro Nacional de Servicios de Diagnóstico en Salud Animal (Cenasa) de la DGSA, se realiza del 21 al 22 de noviembre y aborda temas de salud animal relacionados con la RAM.
Además, especialistas convocados por el Subcomité de RAM-Salud Animal (SCRAM-SA) exponen temas como: Uso responsable de los antimicrobianos, Tendencias de venta, Sustitutos en la alimentación animal y Vacunas como alternativa para reducir el uso de medicamentos.
Posteriormente, del 23 al 24 de noviembre el Centro Nacional de Referencia de Inocuidad y Bioseguridad Agroalimentaria del Senasica, en coordinación con el Consejo de Salubridad General y otras instituciones del Subcomité sobre RAM Ambiental (SCRAM-A), celebrará el foro: “Una Perspectiva Ambiental”, en el que por primera vez en México se hablará de la importancia de la inocuidad de los alimentos para atacar este problema global.
En este evento, especialistas nacionales e internacionales dialogarán sobre Medioambiente y RAM; Bacterias resistentes a antimicrobianos en alimentos y Relación de esta problemática en la pérdida de biodiversidad, entre otros temas.
Ambos encuentros se transmiten a partir de las 10 de la mañana en la página oficial del Senasica https://www.gob.mx/senasica y en sus redes sociales.
En la salud humana la RAM puede representar un problema grave porque el uso indiscriminado de medicamentos provoca que las bacterias, hongos, virus y parásitos se vuelvan resistentes a este tipo de sustancias y, como consecuencia, se torna más difícil combatir las enfermedades causadas por microrganismos.
Lo anterior se debe al manejo inadecuado de antibióticos, antifúngicos, antivirales, antipalúdicos o antihelmínticos tanto en las personas como en los animales por cambio innecesario de tratamientos que no se completen o por la falta de apego a las prescripciones.
Ante ello, los principales organismos internacionales especialistas en salud pública, animal y ambiental han alertado que la resistencia antimicrobiana ya está presente en los ecosistemas, lo que es motivo de preocupación a nivel mundial.
De acuerdo con proyecciones de la Organización Mundial de Salud se estima que para el 2050 las “superbacterias” podrían ser causa de muerte de más de 10 millones de seres humanos cada año.